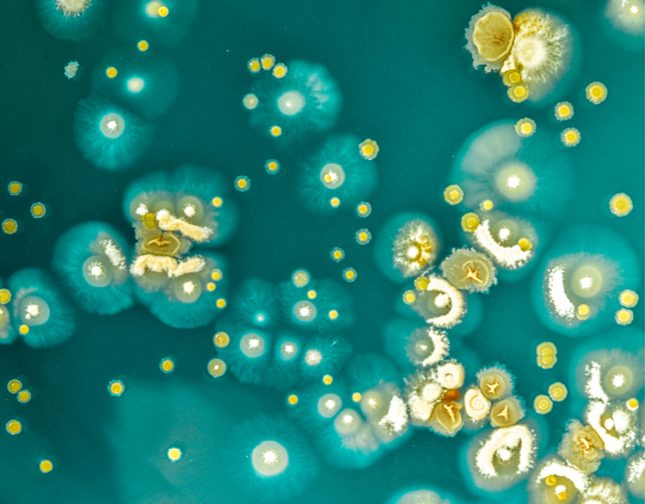
Header

The World Organisation for Animal Health report shows promising trends in the race to fight antimicrobial resistance and preserve the efficacy of these critical medicines.
Recording and analysing data on antimicrobial use is critical to fully understand this multi-faceted rising danger. With the aim of monitoring trends in the animal health sector, WOAH launched an annual data collection process in 2015. The initiative has seen steady and increased engagement from the Members of the Organisation, who have improved their capacity to gather and provide more detailed information over time. Despite the disruptions caused by Covid-19, nearly 160 countries have participated in the last round of data collection, and some of them have also published their information on national platforms. It is to date, the most comprehensive set of information available on the use of antimicrobials in animals.
This sixth report provides a regional and global analysis on the use of antimicrobial in animals in our Members and in non-contiguous territories. It also lists the barriers that countries encountered when trying to collect, analyse and present data.
With reference to the Americas region, 85% of our Members and territories invited submitted their replies, and 71% provided quantitative data.
Useful links
Tripartite AMR Project “Working together to fight antimicrobial resistance”